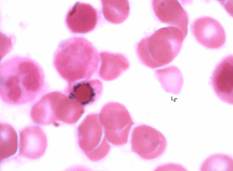
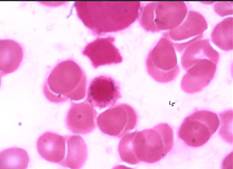

Tinción de Perls: la citoquímica que sobrevive en la era de la hematología moderna. Clave para la elegibilidad a luspatercept en la anemia asociada al SMD
Perls' Stain: the cytochemical test surviving in modern hematology. Key to luspatercept eligibility in MDS-associated anemia
Colimodio, D1, Melchiori P1, Carricondo Emiliano2.
1 Laboratorio Central. Sector Hematología. Hospital Universitario Austral. Bs As - Argentina
2 Servicio de Hematología y Trasplante Hemopoyético. Hospital Universitario Austral. Bs As - Argentina.
Diego Colimodio https://orcid.org/0009-0006-1298-941X
Paulina Melchiori https://orcid.org/0009-0001-4215-4345
Emiliano Carricondo https://orcid.org/0009-0003-2489-8409
Palabras clave: síndrome mielodisplásico,
sideroblastos en anillo,
tinción de Perls,
luspatercept.
Keywords: myelodisplastic,
ring sideroblast,
Perls,
luspatercept.
Introducción
El diagnóstico hematológico en pacientes con anemia y citopenias necesita de una buena integración de hallazgos morfológicos, citoquímicos y moleculares. Aunque los estudios moleculares han revolucionado la clasificación de las neoplasias mieloides, las técnicas citoquímicas tradicionales, como la reacción de Perls (tinción con azul de Prusia), continúan siendo indispensables. La tinción de Perls representa un estudio fundamental debido a su capacidad para visualizar y evaluar de forma directa los depósitos de hierro (hemosiderina) en muestras de aspirado de médula ósea. Su valor reside en ser una técnica sencilla, de rápida implementación en cualquier laboratorio y que ofrece resultados concluyentes en el mismo día.
La técnica se basa en la reacción del ion férrico (Fe3+) con el ferrocianuro de potasio, produciendo el característico color azul de Prusia(1). Los pasos principales son:
- fijación: el extendido de médula ósea se fija con metanol.
- incubación: se realiza con una solución que contiene partes iguales de ferrocianuro de potasio y ácido clorhídrico diluido. El ácido disocia el hierro de sus proteínas de almacenamiento (principalmente hemosiderina), y el ferrocianuro de potasio reacciona con los iones de hierro liberados (Fe3+).
- lavado: se utiliza agua destilada para eliminar el exceso de reactivos.
- contratinción: el método tradicional de contratinción para la tinción de Perls, descrito en manuales clásicos como el de Dacie y Lewis(1), suele emplear la safranina para la visualización de los sideroblastos. Sin embargo, para lograr una mejor visualización y un conteo preciso de los gránulos de hierro, se recomienda utilizar fucsina básica como agente de contratinción.
Los sideroblastos en anillo (SA) son precursores eritroides que exhiben una acumulación y distribución anormal de hierro en las mitocondrias, formando un anillo perinuclear(1,4). La detección del 15% o más de SA en el extendido de médula ósea es un criterio diagnóstico definitorio que impacta directamente en la clasificación.
● Clasificación de la WHO (World Health Organization 2022): define el cuadro como síndrome mielodisplásico con sideroblastos en anillo (SMD-SA) (2).
● Clasificación ICC (International Consensus Classification 2022): lo designa como SMD con mutación en SF3B1, ya que la presencia de SA está fuertemente correlacionada con esta mutación(3).
Mediante microscopia óptica, los SA se definen morfológicamente por la presencia de 5 o más gránulos de hierro de color azul intenso que rodean parcial o totalmente el núcleo, debiendo cubrir al menos un tercio de su circunferencia. La identificación de este patrón morfológico no sólo establece el diagnóstico de SMD-SA, sino que posee implicancias pronósticas y terapéuticas directas, especialmente en la elegibilidad para el tratamiento con luspatercept.
Casos clínicos
A continuación, se presentan tres casos clínicos que demuestran la utilidad de la tinción de Perls en el diagnóstico y manejo de la anemia asociada al SMD-SA.
Caso 1
Paciente masculino de 74 años que se presenta con anemia normocítica severa (Hb: 5.4 g/dL; VCM: 88 fL) y leucopenia (3110 /mm³) con neutropenia leve (1290 /mm³). Se descartan anemias deficitarias. En el medulograma se observan signos de displasia en serie granulocítica y serie roja; y en el estudio por anatomía patológica se evidencia una celularidad del 40% con signos de dishematopoyesis, resultados que también son confirmados mediante la técnica de citometría de flujo multiparamétrica.
La tinción de Perls revela 25% de sideroblastos en anillo. El diagnóstico se confirma como síndrome mielodisplásico, clasificado inicialmente como de muy bajo riesgo (IPSS-R 1.5). La morfología patológica del hierro en los sideroblastos, sumado a otro, define este caso dentro de un subgrupo específico de pacientes con SMD con sideroblastos en anillo.
Caso 2
Paciente masculino de 88 años que presenta anemia crónica macrocítica e hiporregenerativa (Hb: 8.0 g/dL; VCM: 102 /fL). Se descartan anemias deficitarias. El paciente es tratado con múltiples aplicaciones de eritropoyetina sin un aumento claro en sus valores de Hb.
Se realiza una punción-aspiración de médula ósea (PAMO), que revela hipercelularidad medular y cambios displásicos prominentes en las series eritroide y megacariocítica.
La tinción de Perls evidencia un 95% de sideroblastos en anillo. Estos hallazgos morfológicos y citoquímicos son compatibles con un síndrome mielodisplásico con sideroblastos en anillo.
Caso 3
Paciente masculino de 67 años que consulta inicialmente por sobrecarga de hierro (ferritina: 701 ng/mL). Al momento de la evaluación presenta anemia leve normocítica (Hb: 11.0 g/dL; VCM: 92.8 /fL) y neutropenia (950 /mm³).
En el medulograma no se evidencian blastos, aunque la serie granulocítica presenta ligeros cambios de displasia, lo cual coincide con los resultados informados en la citometría de flujo multiparamétrica. Anatomía patológica informa una celularidad del 55% con cambios dishematopoyéticos.
La tinción de Perls finalmente revela hemosiderina positiva y la presencia de un 33% de sideroblastos en anillo, lo cual es fundamental para confirmar el diagnóstico de síndrome mielodisplásico con sideroblastos en anillo. Este caso es clasificado con un muy bajo riesgo (IPSS-R: 1).
Imágenes
|
|
|
|
Figuras A y B. Revisión microscópica a 40X de la técnica de tinción de Perls (Azul de Prusia). Se observa claramente el depósito de hierro medular (hemosiderina) identificado por una coloración azul verdosa característica. Los hematíes se observan de color marrón. |
|
|
|
|
|
|
|
|
|
|
|
|
|
|
Figuras C, D, E, F, G, H, I, J, K. Representación microscópica a 100X de sideroblastos en anillo de los pacientes de caso 1-2-3. Se observan gránulos de hierro de color azul intenso que rodean parcial o totalmente el núcleo. |
||
Conclusiones
La tinción de Perls es una herramienta diagnóstica esencial, rápida y costo efectiva en el síndrome mielodisplásico. La cuantificación de los sideroblastos en anillo, como se evidenció en estos casos (25%, 95% y 33% de SA), no sólo confirma el subtipo SMD-SA, sino que es signo muy importante para predecir la respuesta a luspatercept(5).
Además, ante la imposibilidad de realizar el estudio de la mutación SF3B1, este estudio citoquímico clarifica la conexión fisiopatológica entre la diseritropoyesis y el trastorno del metabolismo del hierro, orientando así el diagnóstico y manejo integral del paciente.
Bibliografía
- Bain BJ, Bates I, Laffan MA, Lewis SM. Dacie and Lewis Practical Haematology. 12th ed. Edinburgh: Elsevier; 2018.
- Arber DA, Orazi A, Hasserjian R et al. The 2016 revision to the World Health Organization classification of myeloid neoplasms and acute leukemia. Blood. 2016;127(20):2391-2405. Blood.
- Arber DA, Orazi A, Hasserjian R, Thiele J, Wood BL, Vyas P et al. International Consensus Classification of Myeloid Neoplasms and Acute Leukemias: integrating morphology, immunology, phenotyping, and genomic data. Blood. 2022 Sep 1;140(11):1200-28.
- Rodak B, Fritsma GA, Keohane E (Eds.). (2023). Rodak's Hematology: Clinical Principles and Applications (7th ed.). Elsevier
- Della Porta MG, Garcia-Manero G, Santini V y col. Luspatercept versus epoetin alfa in erythropoiesis-stimulating agent-naive, transfusion-dependent, lower-risk myelodysplastic syndromes (COMMANDS): primary analysis of a phase 3, open-label, randomized, controlled trial. Lancet Haematol. 2024 Sep;11(9):e646-e658.